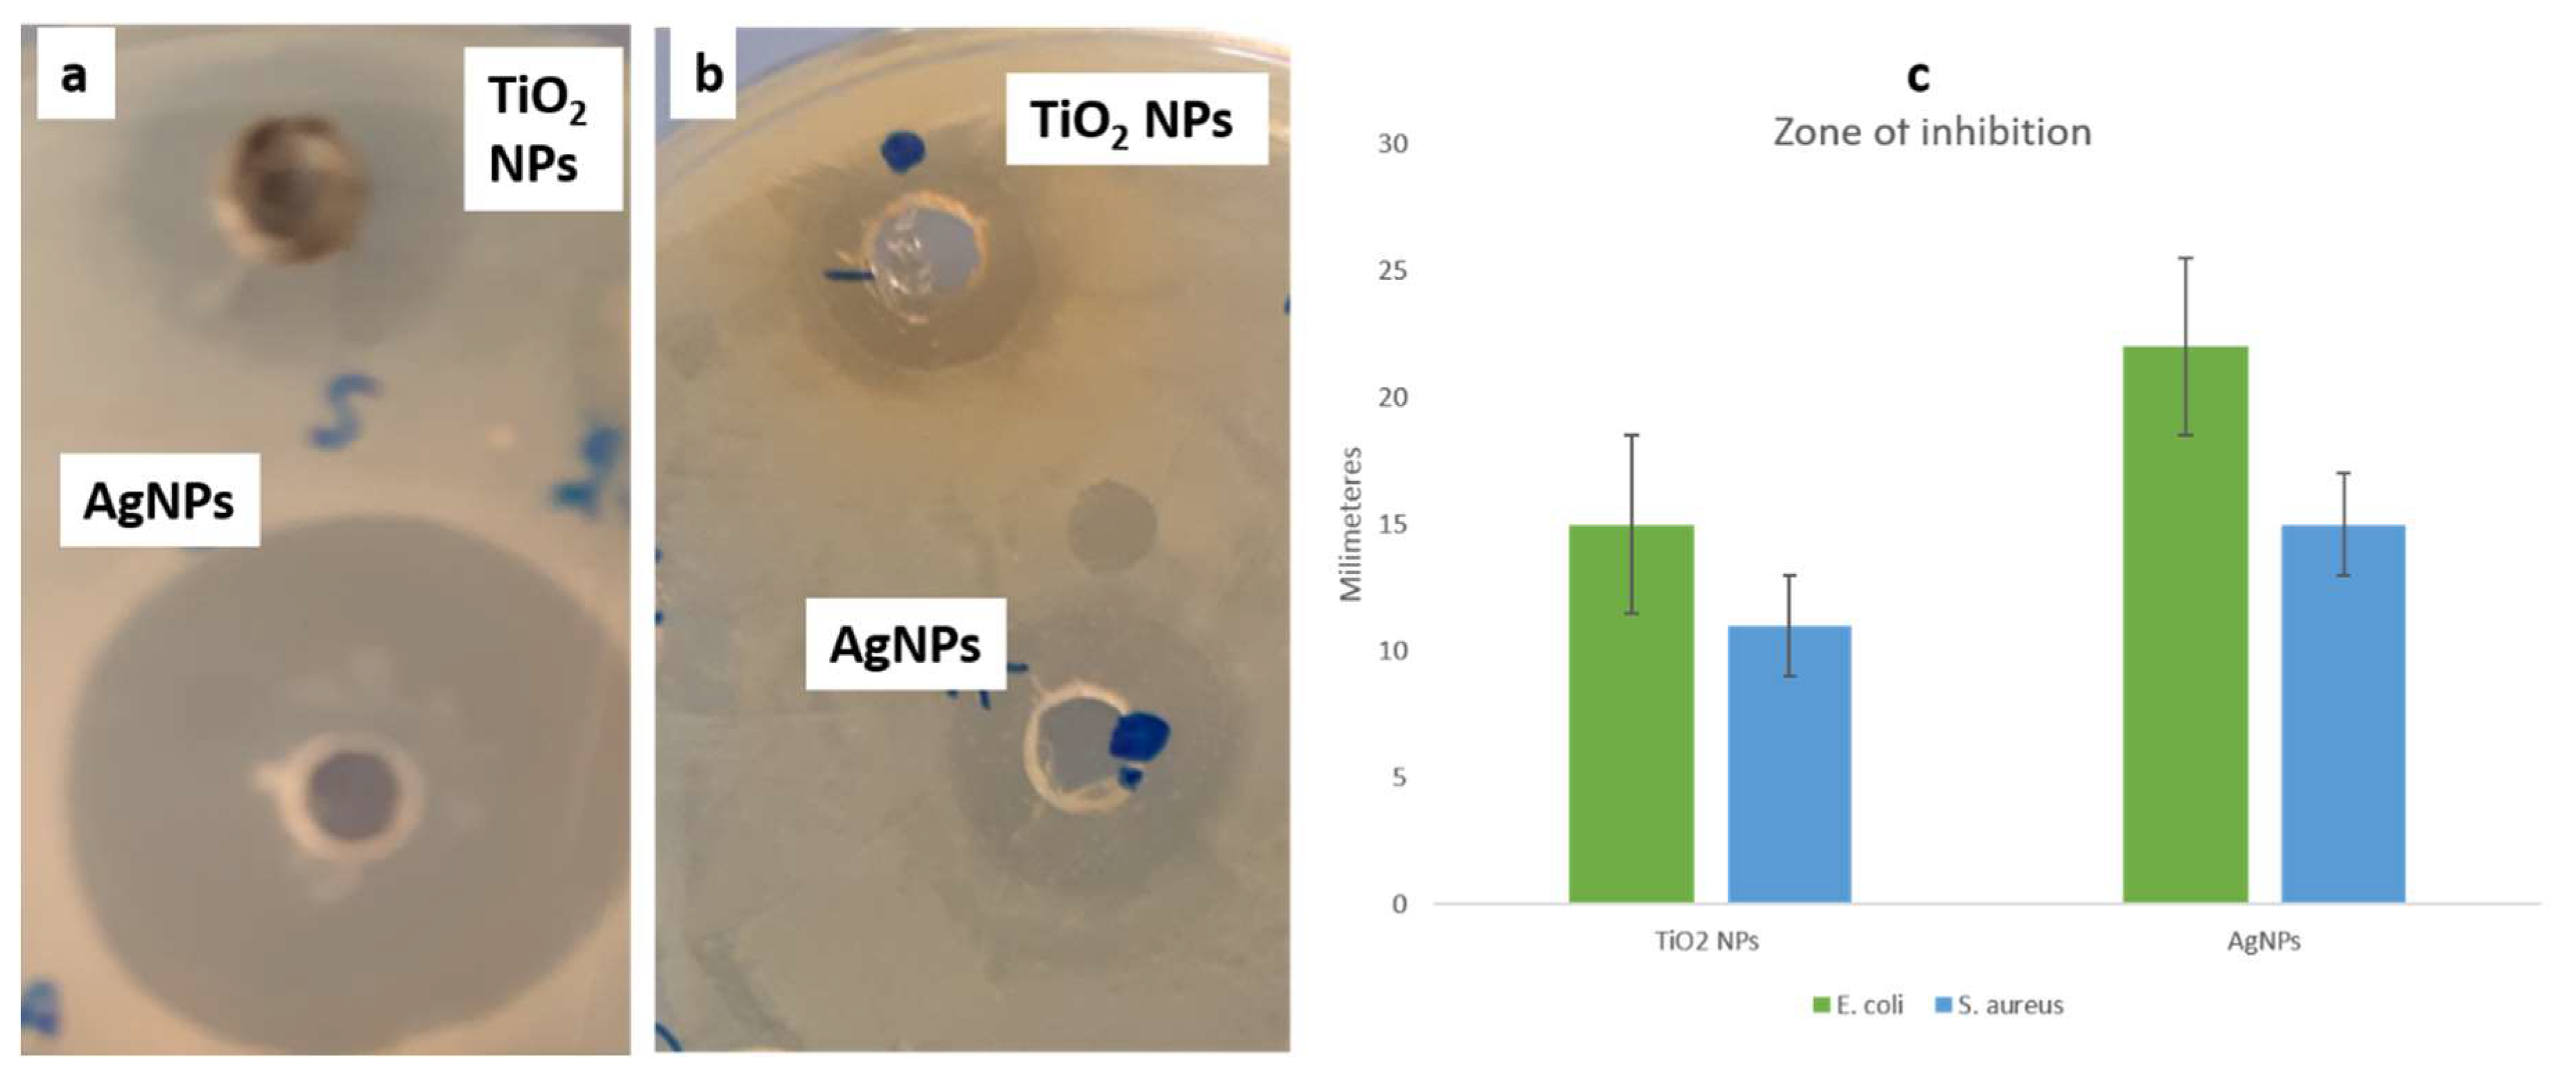
Biomolecules 10 00622 g006

A Wild Fomes fomentarius for Biomediation of One Pot Synthesis of Titanium Oxide and Silver Nanoparticles for Antibacterial and Anticancer Application
Abstract
:1. Introduction
2. Experimental
2.1. Collection, Phenotypic and Genotypic Studies of F. fomentarius
2.1.1. DNA Isolation and PCR
2.1.2. Sequence and Phylogeny Analysis
2.2. Biosynthesis of TiO2 and AgNPs Using Fomes Fomentarius
2.3. Characterization of Biosynthesized TiO2 and Ag NPs
2.4. Antibacterial Activity of Biosynthesized NPs
2.5. Study of Topological Changes in Treated Bacteria by SEM
2.6. Cytotoxic Activity
2.6.1. Cell Culture & Treatments
2.6.2. Cancer Cell Morphology
2.6.3. Cytotoxicity by MTT Assay
2.6.4. Nuclear Staining by DAPI
3. Results and Discussion
3.1. Phenotypic and Genotypic Studies of F. fomentarius
3.2. Characterization of TiO2 and AgNPs
3.3. Antibacterial Activity of Synthesized NPs
3.4. Anticancer Activity of Synthesized NPs
4. Conclusions
Supplementary Materials
Author Contributions
Funding
Conflicts of Interest
References
- Vetchinkina, E.; Loshchinina, E.; Kupryashina, M.; Burov, A.; Pylaev, T.; Nikitina, V. Green synthesis of nanoparticles with extracellular and intracellular extracts of basidiomycetes. PeerJ 2018, 6, e5237. [Google Scholar] [CrossRef] [PubMed]
- Prabhu, S.; Poulose, E.K. Silver nanoparticles: Mechanism of antimicrobial action, synthesis, medical applications, and toxicity effects. Int. Nano Lett. 2012, 2, 32. [Google Scholar] [CrossRef] [Green Version]
- Griffith, M.; Udekwu, K.; Gkotzis, S.; Mah, T.; Alarcon, E. Silver Nanoparticle Applications. In the Fabrication and Design of Medical and Biosensing Devices; Springer International Publishing: Cham, Switzerland, 2015. [Google Scholar]
- Wei, L.; Lu, J.; Xu, H.; Patel, A.; Chen, Z.-S.; Chen, G. Silver nanoparticles: Synthesis, properties, and therapeutic applications. Drug Discov. Today 2015, 20, 595–601. [Google Scholar] [CrossRef] [Green Version]
- Dobrucka, R. Synthesis of titanium dioxide nanoparticles using Echinacea purpurea herba. Iran. J. Pharm. Res. 2017, 16, 756. [Google Scholar]
- Peng, D.; Zhang, J.; Liu, Q.; Taylor, E.W. Size effect of elemental selenium nanoparticles (Nano-Se) at supranutritional levels on selenium accumulation and glutathione S-transferase activity. J. Inorg. Biochem. 2007, 101, 1457–1463. [Google Scholar] [CrossRef] [PubMed]
- Ivask, A.; Kurvet, I.; Kasemets, K.; Blinova, I.; Aruoja, V.; Suppi, S.; Vija, H.; Käkinen, A.; Titma, T.; Heinlaan, M.; et al. Size-Dependent Toxicity of Silver Nanoparticles to Bacteria, Yeast, Algae, Crustaceans and Mammalian Cells In Vitro. PLoS ONE 2014, 9, e102108. [Google Scholar] [CrossRef] [PubMed]
- Shang, L.; Nienhaus, K.; Nienhaus, G.U. Engineered nanoparticles interacting with cells: Size matters. J. Nanobiotechnol. 2014, 12, 5. [Google Scholar] [CrossRef] [Green Version]
- Li, W.; Xu, X.; Li, W.; Liu, P.; Zhao, Y.; Cen, Q.; Chen, M. One-step synthesis of Ag nanoparticles for fabricating highly conductive patterns using infrared sintering. J. Mater. Res. Technol. 2020, 9, 142–151. [Google Scholar] [CrossRef]
- Chin, S.; Park, E.; Kim, M.; Bae, G.-N.; Jurng, J. Synthesis and photocatalytic activity of TiO2 nanoparticles prepared by chemical vapor condensation method with different precursor concentration and residence time. J. Colloid Interface Sci. 2011, 362, 470–476. [Google Scholar] [CrossRef]
- Narayanan, K.B.; Sakthivel, N. Green synthesis of biogenic metal nanoparticles by terrestrial and aquatic phototrophic and heterotrophic eukaryotes and biocompatible agents. Adv. Colloid Interface Sci. 2011, 169, 59–79. [Google Scholar] [CrossRef]
- Vetchinkina, E.P.; Loshchinina, E.A.; Vodolazov, I.R.; Kursky, V.F.; Dykman, L.A.; Nikitina, V.E. Biosynthesis of nanoparticles of metals and metalloids by basidiomycetes. Preparation of gold nanoparticles by using purified fungal phenol oxidases. Appl. Microbiol. Biotechnol. 2017, 101, 1047–1062. [Google Scholar] [CrossRef] [PubMed]
- Ahmed, S.; Annu; Ikram, S.; Yudha, S.S. Biosynthesis of gold nanoparticles: A green approach. J. Photochem. Photobiol. B Biol. 2016, 161, 141–153. [Google Scholar] [CrossRef]
- Molnár, Z.; Bódai, V.; Szakacs, G.; Erdélyi, B.; Fogarassy, Z.; Sáfrán, G.; Varga, T.; Kónya, Z.; Tóth-Szeles, E.; Szűcs, R. Green synthesis of gold nanoparticles by thermophilic filamentous fungi. Sci. Rep. 2018, 8, 3943. [Google Scholar] [CrossRef] [PubMed]
- Rehman, S.; Jermy, B.R.; Akhtar, S.; Borgio, J.F.; Abdul Azeez, S.; Ravinayagam, V.; Al Jindan, R.; Alsalem, Z.H.; Buhameid, A.; Gani, A. Isolation and characterization of a novel thermophile; Bacillus haynesii, applied for the green synthesis of ZnO nanoparticles. Artif. Cells Nanomed. Biotechnol. 2019, 47, 2072–2082. [Google Scholar] [CrossRef] [PubMed] [Green Version]
- Gudikandula, K.; Vadapally, P.; Charya, M.S. Biogenic synthesis of silver nanoparticles from white rot fungi: Their characterization and antibacterial studies. OpenNano 2017, 2, 64–78. [Google Scholar] [CrossRef]
- Mohseni, M.S.; Khalilzadeh, M.A.; Mohseni, M.; Hargalani, F.Z.; Getso, M.I.; Raissi, V.; Raiesi, O. Green synthesis of Ag nanoparticles from pomegranate seeds extract and synthesis of Ag-Starch nanocomposite and characterization of mechanical properties of the films. Biocatal. Agric. Biotechnol. 2020, 25, 101569. [Google Scholar] [CrossRef]
- Thakur, B.; Kumar, A.; Kumar, D. Green synthesis of titanium dioxide nanoparticles using Azadirachta indica leaf extract and evaluation of their antibacterial activity. South Afr. J. Bot. 2019, 124, 223–227. [Google Scholar] [CrossRef]
- Zied, D.C.; Pardo-Giménez, A. Edible and Medicinal Mushrooms: Technology and Applications; John Wiley & Sons: Hoboken, NJ, USA, 2017. [Google Scholar]
- Krueger, D. Monographic Studies in the Genus Polyporus (Basidiomycotina). Available online: https://trace.tennessee.edu/utk_graddiss/2135/ (accessed on 7 March 2020).
- Castro, M.E.; Cottet, L.; Castillo, A. Biosynthesis of gold nanoparticles by extracellular molecules produced by the phytopathogenic fungus Botrytis cinerea. Mater. Lett. 2014, 115, 42–44. [Google Scholar] [CrossRef]
- Balashanmugam, P.; Santhosh, S.; Giyaullah, H.; Balakumaran, M.; Kalaichelvan, P. Mycosynthesis, characterization and antibacterial activity of silver nanoparticles from Microporusxanthopus: A macro Mushroom. Int. J. Innov. Res. Sci. Eng. Technol. 2013, 2, 6262–6270. [Google Scholar]
- Mohanta, Y.; Nayak, D.; Biswas, K.; Singdevsachan, S.; Abd_Allah, E.; Hashem, A.; Alqarawi, A.; Yadav, D.; Mohanta, T. Silver nanoparticles synthesized using wild mushroom show potential antimicrobial activities against food borne pathogens. Molecules 2018, 23, 655. [Google Scholar] [CrossRef] [Green Version]
- Felsenstein, J. PHYLIP (Phylogeny Inference Package), Version 3.5 c. Available online: http://www.dbbm.fiocruz.br/molbiol/main.html (accessed on 7 March 2020).
- Dresch, P.; Rosam, K.; Grienke, U.; Rollinger, J.M.; Peintner, U. Fungal strain matters: Colony growth and bioactivity of the European medicinal polypores Fomes fomentarius, Fomitopsis pinicola and Piptoporus betulinus. AMB Express 2015, 5, 4. [Google Scholar] [CrossRef] [PubMed] [Green Version]
- Rehman, S.; Ansari, M.A.; Alzohairy, M.A.; Alomary, M.N.; Jermy, B.R.; Shahzad, R.; Tashkandi, N.; Alsalem, Z.H. Antibacterial and Antifungal Activity of Novel Synthesized Neodymium-Substituted Cobalt Ferrite Nanoparticles for Biomedical Application. Processes 2019, 7, 714. [Google Scholar] [CrossRef] [Green Version]
- Khan, F.; Akhtar, S.; Almofty, S.; Almohazey, D.; Alomari, M. FMSP-nanoparticles induced cell death on human breast adenocarcinoma cell line (MCF-7 Cells): Morphometric analysis. Biomolecules 2018, 8, 32. [Google Scholar] [CrossRef] [PubMed] [Green Version]
- Anthony, K.J.P.; Murugan, M.; Jeyaraj, M.; Rathinam, N.K.; Sangiliyandi, G. Synthesis of silver nanoparticles using pine mushroom extract: A potential antimicrobial agent against E. coli and B. subtilis. J. Ind. Eng. Chem. 2014, 20, 2325–2331. [Google Scholar] [CrossRef]
- Khatami, M.; Sharifi, I.; Nobre, M.A.; Zafarnia, N.; Aflatoonian, M.R. Waste-grass-mediated green synthesis of silver nanoparticles and evaluation of their anticancer, antifungal and antibacterial activity. Green Chem. Lett. Rev. 2018, 11, 125–134. [Google Scholar]
- Lokhande, A.; Babar, P.; Karade, V.; Jang, J.; Lokhande, V.; Lee, D.; Kim, I.-C.; Patole, S.; Qattan, I.; Lokhande, C. A viable green route to produce Ag nanoparticles for antibacterial and electrochemical supercapacitor applications. Mater. Today Chem. 2019, 14, 100181. [Google Scholar] [CrossRef]
- Manzoor-ul-Haq, R.V.; Singh, D.; Singh, A.K.; Ninganagouda, S.; Hiremath, J. Dried mushroom Agaricus bisporus mediated synthesis of silver nanoparticles from Bandipora District (Jammu and Kashmir) and their efficacy against methicillin resistant Staphylococcus aureus (MRSA) strains. Nanosci. Nanotechnol. Int. J. 2015, 5, 1–8. [Google Scholar]
- Ravichandran, A.; Subramanian, P.; Manoharan, V.; Muthu, T.; Periyannan, R.; Thangapandi, M.; Ponnuchamy, K.; Pandi, B.; Marimuthu, P.N. Phyto-mediated synthesis of silver nanoparticles using fucoidan isolated from Spatoglossum asperum and assessment of antibacterial activities. J. Photochem. Photobiol. B Biol. 2018, 185, 117–125. [Google Scholar] [CrossRef]
- Kareem, A.A.; Al-Hamadani, A.H. Combination Effect of Edible Mushroom–Sliver Nanoparticles and Antibiotics against selected Multidrug Biofilm Pathogens. Iraq Med. J. 2018, 1, 68–74. [Google Scholar]
- Nithya, R.; Ragunathan, R. Synthesis of silver nanoparticle using Pleurotus sajor caju and its antimicrobial study. Dig. J. Nanomater. Biostruct. 2009, 4, 623–629. [Google Scholar]
- Birla, S.; Tiwari, V.; Gade, A.; Ingle, A.; Yadav, A.; Rai, M. Fabrication of silver nanoparticles by Phoma glomerata and its combined effect against Escherichia coli, Pseudomonas aeruginosa and Staphylococcus aureus. Lett. Appl. Microbiol. 2009, 48, 173–179. [Google Scholar] [CrossRef] [PubMed]
- Panáček, A.; Smékalová, M.; Kilianová, M.; Prucek, R.; Bogdanová, K.; Večeřová, R.; Kolář, M.; Havrdová, M.; Płaza, G.A.; Chojniak, J. Strong and nonspecific synergistic antibacterial efficiency of antibiotics combined with silver nanoparticles at very low concentrations showing no cytotoxic effect. Molecules 2016, 21, 26. [Google Scholar] [CrossRef] [PubMed] [Green Version]
- Balaji Raja, R.; Singh, P. Synergistic effect of silver nanoparticles with the cephalexin antibiotic against the test strains. Biores Bull. 2012, 2, 171–179. [Google Scholar]
- Swathi, N.; Sandhiya, D.; Rajeshkumar, S.; Lakshmi, T. Green synthesis of titanium dioxide nanoparticles using Cassia fistula and its antibacterial activity. Int. J. Res. Pharm. Sci. 2019, 10, 856–860. [Google Scholar] [CrossRef]
- Ashour, A.; El-Batal, A.I.; Maksoud, M.A.; El-Sayyad, G.S.; Labib, S.; Abdeltwab, E.; El-Okr, M. Antimicrobial activity of metal-substituted cobalt ferrite nanoparticles synthesized by sol–gel technique. Particuology 2018, 40, 141–151. [Google Scholar] [CrossRef]
- Al-Bahrani, R.; Raman, J.; Lakshmanan, H.; Hassan, A.A.; Sabaratnam, V. Green synthesis of silver nanoparticles using tree oyster mushroom Pleurotus ostreatus and its inhibitory activity against pathogenic bacteria. Mater. Lett. 2017, 186, 21–25. [Google Scholar] [CrossRef]
- Anandan, K.; Rajendran, V. Size controlled synthesis of SnO2 nanoparticles: Facile solvothermal process. J. Non-Oxide Glasses 2010, 2, 83–89. [Google Scholar]
- Wang, C.; Kim, Y.J.; Singh, P.; Mathiyalagan, R.; Jin, Y.; Yang, D.C. Green synthesis of silver nanoparticles by Bacillus methylotrophicus, and their antimicrobial activity. Artif. Cells Nanomed. Biotechnol. 2016, 44, 1127–1132. [Google Scholar]
- Lusvardi, G.; Barani, C.; Giubertoni, F.; Paganelli, G. Synthesis and characterization of TiO2 nanoparticles for the reduction of water pollutants. Materials 2017, 10, 1208. [Google Scholar] [CrossRef] [Green Version]
- Gurunathan, S.; Lee, K.J.; Kalishwaralal, K.; Sheikpranbabu, S.; Vaidyanathan, R.; Eom, S.H. Antiangiogenic properties of silver nanoparticles. Biomaterials 2009, 30, 6341–6350. [Google Scholar] [CrossRef]
- Martins, D.; Frungillo, L.; Anazzetti, M.C.; Melo, P.S.; Durán, N. Antitumoral activity of L-ascorbic acid-poly- D,L-(lactide-co-glycolide) nanoparticles containing violacein. Int. J. Nanomed. 2010, 5, 77–85. [Google Scholar] [CrossRef] [Green Version]
- Chatterjee, A.; Nishanthini, D.; Sandhiya, N.; Abraham, J. Biosynthesis of titanium dioxide nanoparticles using Vigna radiata. Asian J. Pharm. Clin. Res. 2016, 9, 1–4. [Google Scholar]
- Suker, D.K.; Albadran, R.M. Cytotoxic effects of titanium dioxide nanoparticles on rat embryo fibroblast REF-3 cell line in vitro. Eur. J. Exp. Biol. 2013, 3, 354–363. [Google Scholar]
- Barabadi, H.; Ovais, M.; Shinwari, Z.K.; Saravanan, M. Anti-cancer green bionanomaterials: Present status and future prospects. Green Chem. Lett. Rev. 2017, 10, 285–314. [Google Scholar] [CrossRef] [Green Version]

| Accession Number | BLAST Match Sequence | ||
|---|---|---|---|
| Reference Accession Number | Coverage | Maximum Identity | |
| MK635351 | JX126894.1 Fomes fomentarius | 100% | 100% |
| KU1391991.1 Fomes fomentarius | 100% | 100% | |
| MK9101131 Fomes fomentarius | 100% | 99.82% | |
| KU863082.1 Fomes fomentarius | 100% | 99.82% | |
| KX065943.1 Fomes fomentarius | 100% | 99.82% | |
© 2020 by the authors. Licensee MDPI, Basel, Switzerland. This article is an open access article distributed under the terms and conditions of the Creative Commons Attribution (CC BY) license (http://creativecommons.org/licenses/by/4.0/).
Share and Cite
Rehman, S.; Farooq, R.; Jermy, R.; Mousa Asiri, S.; Ravinayagam, V.; Al Jindan, R.; Alsalem, Z.; Shah, M.A.; Reshi, Z.; Sabit, H.; et al. A Wild Fomes fomentarius for Biomediation of One Pot Synthesis of Titanium Oxide and Silver Nanoparticles for Antibacterial and Anticancer Application. Biomolecules 2020, 10, 622. https://doi.org/10.3390/biom10040622
Rehman S, Farooq R, Jermy R, Mousa Asiri S, Ravinayagam V, Al Jindan R, Alsalem Z, Shah MA, Reshi Z, Sabit H, et al. A Wild Fomes fomentarius for Biomediation of One Pot Synthesis of Titanium Oxide and Silver Nanoparticles for Antibacterial and Anticancer Application. Biomolecules. 2020; 10(4):622. https://doi.org/10.3390/biom10040622
Chicago/Turabian StyleRehman, Suriya, Romana Farooq, Rabindran Jermy, Sarah Mousa Asiri, Vijaya Ravinayagam, Reem Al Jindan, Zainab Alsalem, Manzoor A. Shah, Zafar Reshi, Hussein Sabit, and et al. 2020. "A Wild Fomes fomentarius for Biomediation of One Pot Synthesis of Titanium Oxide and Silver Nanoparticles for Antibacterial and Anticancer Application" Biomolecules 10, no. 4: 622. https://doi.org/10.3390/biom10040622
APA StyleRehman, S., Farooq, R., Jermy, R., Mousa Asiri, S., Ravinayagam, V., Al Jindan, R., Alsalem, Z., Shah, M. A., Reshi, Z., Sabit, H., & Alam Khan, F. (2020). A Wild Fomes fomentarius for Biomediation of One Pot Synthesis of Titanium Oxide and Silver Nanoparticles for Antibacterial and Anticancer Application. Biomolecules, 10(4), 622. https://doi.org/10.3390/biom10040622






